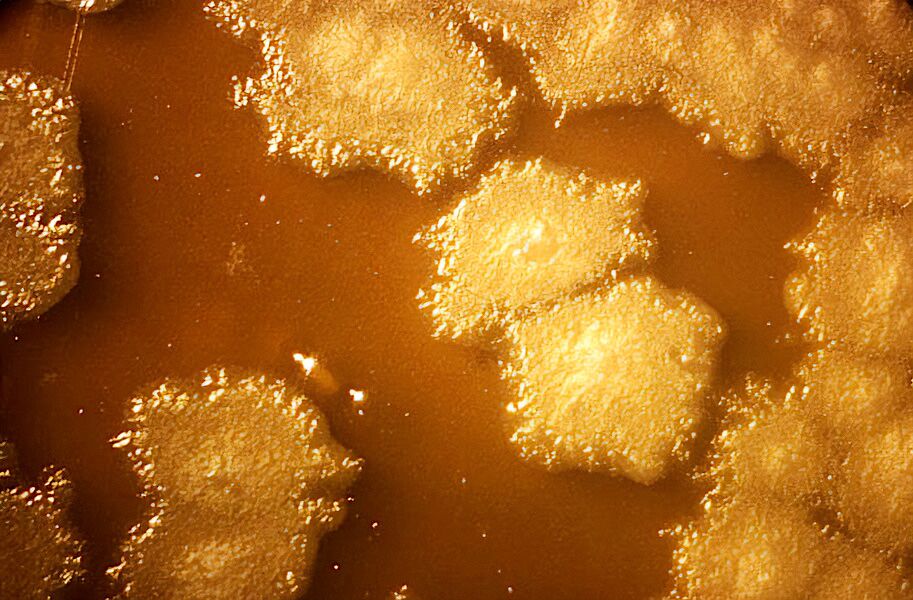
Scientists create bacteria that defeat cancer by devouring tumors (from the inside out)

Petri dish with a culture of Clostridium sporogenes
A genetically altered common soil bacterium can automatically identify an environment with excess nutrients and no oxygen — a sign of the presence of a tumor — and begin to “eat” these nutrients, destroying the tumor.
There are certain things that bacteria don’t like to do on their own. Some resource-intensive activities — like building the structure of a biofilm or releasing virulence factors — only make sense when there are enough bacteria around to share the effort.
This is where the call comes in quorum sensingwhich works as a kind of automatic bacterial census. Each individual cell releases a chemical signal to which it is also sensitive, explains .
When this signal reaches, in the surrounding environment, a concentration that indicates the presence of a significant number of bacteriagene expression changes.
Researchers at the University of Waterloo recently turned to the quorum sensing in his attempt to transform a common soil bacterium, Clostridium sporogenesin an effective cancer treatment that is capable of “eat” tumors from the inside out.
The results of their study were recently presented in a published in ACS Synthetic Biology.
“Bacterial spores enter the tumorwhere they find an environment with lots of nutrients and without oxygen, which is precisely what this organism prefers, and then they begin to consume these nutrients and grow”, explained the chemical engineer Marc Aucoinco-author of the study, in .
“So, we start to colonize this central space, and the bacteria are essentially releasing the organism from the tumor”, adds the researcher.
The problem with this approach is that the C. sporogenes is a strict anaerobicwhich means that does not tolerate oxygen. Although it can thrive in the oxygen-poor environment within a tumor, oxygenated tissues at the outer margins would be fatal.
To overcome this obstacle, researchers went to look for a gene to another microorganism capable of tolerating oxygen. When connecting it to a quorum sensingcan guarantee that this gene is only activated after a sufficient number of bacteria have multiplied within the tumor itself.
“Com use of synthetic biologywe built something similar to an electrical circuit, but instead of wires we used fragments of DNA”, explains the mathematician Brian Ingallslead author of the study.
“Each fragment has its function. When they are assembled correctly, they form a system that works predictably”, explains the researcher.
Now that they know this approach works, researchers have clinical trials in their sights. And one day, instead of cancer consuming our body from the inside out, these genetically modified microorganisms could return them the favor.